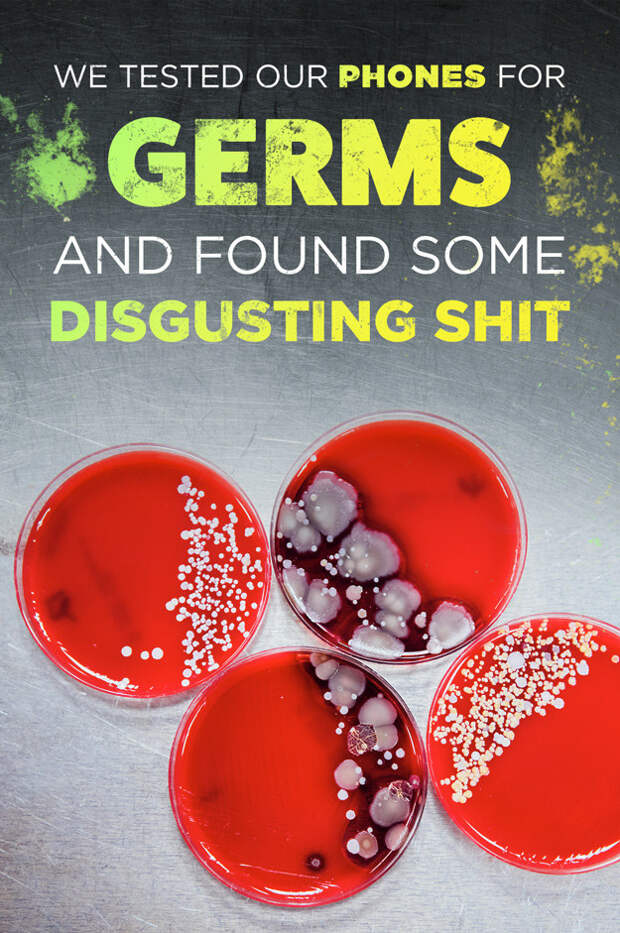
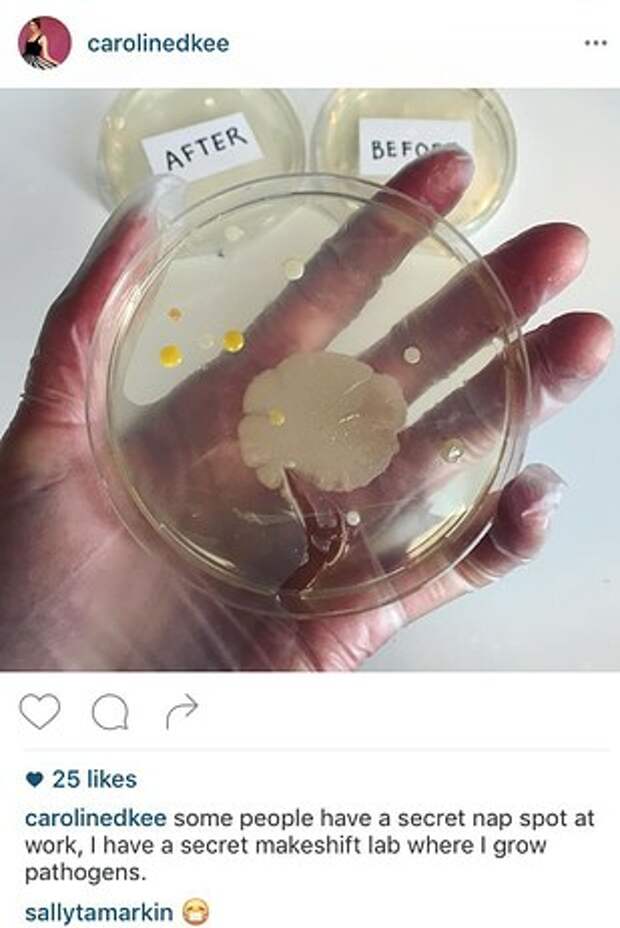

Our office is a literal petri dish, help.

Taylor Miller / Andrew Richard / Via BuzzFeed

Caroline Kee

Caroline Kee
На информационном ресурсе применяются рекомендательные технологии (информационные технологии предоставления информации на основе сбора, систематизации и анализа сведений, относящихся к предпочтениям пользователей сети "Интернет", находящихся на территории Российской Федерации)
Our office is a literal petri dish, help.
Taylor Miller / Andrew Richard / Via BuzzFeed

Caroline Kee
Caroline Kee
Понравилась статья? Подпишитесь на канал, чтобы быть в курсе самых интересных материалов
Подписаться